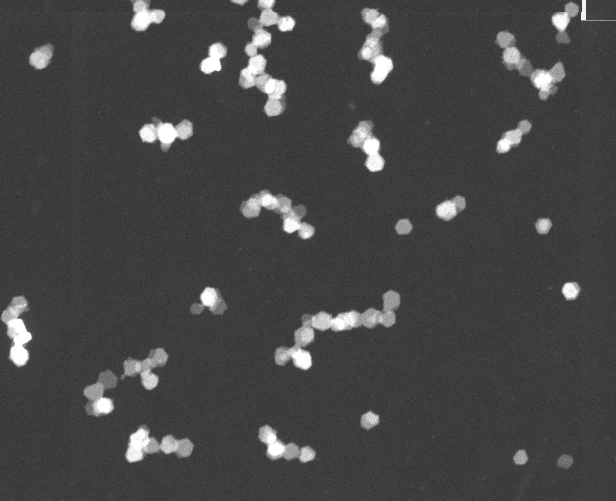

Research Images
 Self-assembley of hexagonal Bi2Te3 nanosheets on mica imaged by high-speed AFM
Self-assembley of hexagonal Bi2Te3 nanosheets on mica imaged by high-speed AFM_cut.jpg) AFM of single layer TiS2 nanoshseets on mica
AFM of single layer TiS2 nanoshseets on mica Scanning transmission electron microscopy of self assembled Bi2Te3 nanosheets deposited from solution
Scanning transmission electron microscopy of self assembled Bi2Te3 nanosheets deposited from solution Artist impression of a nanosheet solution
Artist impression of a nanosheet solution Potassium-intercalated Bi2Te3 spotaneously dissolving in DMF over 2 weeks
Potassium-intercalated Bi2Te3 spotaneously dissolving in DMF over 2 weeks Artist impression of superconducting graphene sheets (credit SLAC)
Artist impression of superconducting graphene sheets (credit SLAC) The band structure of heavily electron doped grpahite revealed by ARPES, showing the 2D graphitic pi* band and the 3D intercalant-derived IL band
The band structure of heavily electron doped grpahite revealed by ARPES, showing the 2D graphitic pi* band and the 3D intercalant-derived IL band Optical micrograph of Mg doped bilayer graphene
Optical micrograph of Mg doped bilayer graphene TEM (left) and electron diffraction (right) of single crystal, hexagonal Bi2Te3 nanohsheets deposited from solution
TEM (left) and electron diffraction (right) of single crystal, hexagonal Bi2Te3 nanohsheets deposited from solution Spotaneous dissolution taken over 2 days (left) of luminescent, hexagonal carbon nitride nanosheets (right)
Spotaneous dissolution taken over 2 days (left) of luminescent, hexagonal carbon nitride nanosheets (right) Raw STM data of the charge density wave on the graphene sheets of CaC6
Raw STM data of the charge density wave on the graphene sheets of CaC6 Charge density waves in CaC6
Charge density waves in CaC6 Stage 1 potassium intercalated graphite (madagascan flake graphite), KC8
Stage 1 potassium intercalated graphite (madagascan flake graphite), KC8 Potassium intercalated graphite (graphoil), KC8
Potassium intercalated graphite (graphoil), KC8 Intercalated graphite KC24(NH3)
Intercalated graphite KC24(NH3) High surface area large, crystallite size exfoliated graphite
High surface area large, crystallite size exfoliated graphite Calcium doped graphene (top left) and graphene hBN laminates
Calcium doped graphene (top left) and graphene hBN laminates Li dissolved in liquid ammonia
Li dissolved in liquid ammonia C60 anions in ammonia from neutron diffraction
C60 anions in ammonia from neutron diffraction 2D ammonia solvent probability density around dissolved C60 anions from neutron diffraction
2D ammonia solvent probability density around dissolved C60 anions from neutron diffraction 1D probability distribution functions of ammonia around C60 anions from neutron diffraction
1D probability distribution functions of ammonia around C60 anions from neutron diffraction Structure of benzene from neutron diffraction
Structure of benzene from neutron diffraction Monte carlo simulation of SWNT anions dissolved in liquid ammonia
Monte carlo simulation of SWNT anions dissolved in liquid ammonia C60 anions in ammonia from modelled diffraction data
C60 anions in ammonia from modelled diffraction data Schematic of the CDW on Ca-doped graphite
Schematic of the CDW on Ca-doped graphite Monte Carlo simulation THF molecules around dissolved graphene sheets
Monte Carlo simulation THF molecules around dissolved graphene sheets Na-Single Walled Carbon Nanotubes dissolving in DMF
Na-Single Walled Carbon Nanotubes dissolving in DMF K-Bi2Te3dissolving
K-Bi2Te3dissolving Intercalated materials we make
Intercalated materials we makePhosphorene Nanoribbons
 Stitched HS-AFM image of phosopherene nanoribbon (yellow) on a graphite substrate
Stitched HS-AFM image of phosopherene nanoribbon (yellow) on a graphite substrate AFM micrographs of 1-5 layer high phosphorene nanoribbons
AFM micrographs of 1-5 layer high phosphorene nanoribbons AFM of PNRs
AFM of PNRs TEM of 3 nm wide PNR
TEM of 3 nm wide PNR TEM of PNR draped on a holey carbon support
TEM of PNR draped on a holey carbon support AFM of a 7 layer PNR (on a graphite surface) seamlessly spliting into a 2 and 5 layer
AFM of a 7 layer PNR (on a graphite surface) seamlessly spliting into a 2 and 5 layer TEM of PNRs forming from a larger 2D phosphorene sheet
TEM of PNRs forming from a larger 2D phosphorene sheet TEM of twisted PNR
TEM of twisted PNRExperimental Techniques
 I05 ARPES beamline at Diamond Light Source, UK used for electronic structure measurements
I05 ARPES beamline at Diamond Light Source, UK used for electronic structure measurements ESRF Synchnotron and ILL Neutron Source in Grenoble, France both used to probe the structure, excitations and dynamics
of the materials we create.
ESRF Synchnotron and ILL Neutron Source in Grenoble, France both used to probe the structure, excitations and dynamics
of the materials we create. Target Station 1 at the ISIS Neutron and Muon Source, UK, we use elastic (wide and small angle), inelastic, quasi-elastic and muon spectroscopy.
Target Station 1 at the ISIS Neutron and Muon Source, UK, we use elastic (wide and small angle), inelastic, quasi-elastic and muon spectroscopy. High speed AFM at Bristol built by Oliver Payton and Loren Picco
High speed AFM at Bristol built by Oliver Payton and Loren Picco Titan electron microscope at Imperial College London
Titan electron microscope at Imperial College London Physical Properties Measurement System, used to measure AC magnetistaion, resistivity and heat capacity as a function of field and temperature
Physical Properties Measurement System, used to measure AC magnetistaion, resistivity and heat capacity as a function of field and temperature Magnetic Properties Measurement System, used to measure DC magnetistaion as a function of field and temperature
Magnetic Properties Measurement System, used to measure DC magnetistaion as a function of field and temperature 'Low temperature' UHV Scanning Tunnelling Microscope at the London Centre for Nanotechnology
'Low temperature' UHV Scanning Tunnelling Microscope at the London Centre for Nanotechnology The incredible resonant inelastic X-ray scattering I21 beamline at Diamond light source.
The incredible resonant inelastic X-ray scattering I21 beamline at Diamond light source.  The NIMROD neutron diffractometer dectector bank at TS2 at ISIS Neutron and Muon Source, capable of measuring over an enormous Q-range for small and wide angle measurements.
We use this machine, in combination with modelling-based refinement of diffraction data to study local and long range order in liquids.
The NIMROD neutron diffractometer dectector bank at TS2 at ISIS Neutron and Muon Source, capable of measuring over an enormous Q-range for small and wide angle measurements.
We use this machine, in combination with modelling-based refinement of diffraction data to study local and long range order in liquids. Candle stick and sample changer on the SANDALS instrument, ISIS Neutron and Muon Source
Candle stick and sample changer on the SANDALS instrument, ISIS Neutron and Muon Source Our Raman spectrometer with mapping stage, three laser lines, low temperature capabilities
Our Raman spectrometer with mapping stage, three laser lines, low temperature capabilities We have two gloveboxes for handling air-sensitive materials
We have two gloveboxes for handling air-sensitive materials







